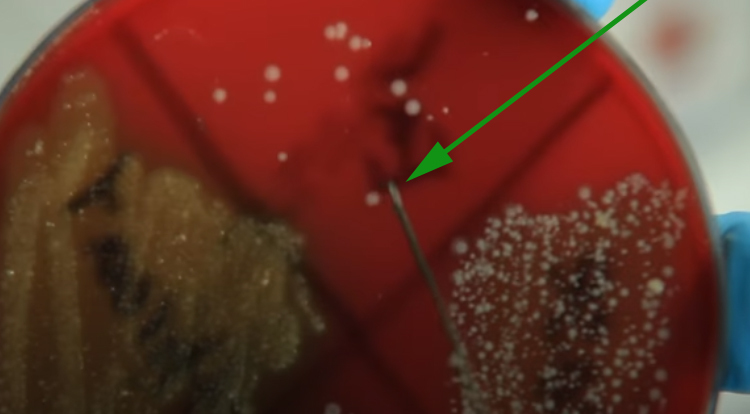

What organisms is being stained here?
A) Staphylococcus
B) Stergenous
C) None of these
D) Sinous

Correct Answer:
A) Staphylococcus
What direction is this slide placed when moved in the direction of the arrow?
A) None of these
B) Upside-down
C) Right-side up
D) Sideways

Correct Answer:
B) Upside-down
What is being placed on the slide?
A) Saline solution
B) Bacteria
C) DI water
D) Chemical mixture

Correct Answer:
C) DI water
What is this tool called?
A) Subcutaneous fascia
B) Inoculation loop
C) Bunsen burner
D) Heat tool

Correct Answer:
B) Inoculation loop
What is occurring at this step?
A) Transfer of agar
B) Transfer of bacteria
C) Transfer of DI water
D) None of these
Correct Answer:
B) Transfer of bacteria
It is important to completely fill the circle here with the mixture of water and bacteria.
A) Yes
B) None of these
C) Only sometimes
D) No

Correct Answer:
A) Yes
What is occurring during this step?
A) Air drying at lowered temperatures
B) None of these
C) Air drying at room temperature
D) Air drying at elevated temperatures

Correct Answer:
C) Air drying at room temperature
How many times does this slide pass over the heat?
A) 3
B) 2
C) 1
D) 4

Correct Answer:
A) 3
Safranine will stain bacterial cells what color?
A) Purple
B) Red
C) Blue
D) Green

Correct Answer:
B) Red
What objective power do you begin with when looking at a slide?
A) Lowest
B) Zero
C) Highest
D) Medium

Correct Answer:
A) Lowest
Cell membranes protect:
A) Organelles
B) All of these
C) Molecules it needs to survive
D) Nucleus

Correct Answer:
B) All of these
According to the video, what is the name of this structure as shown by the arrow?
A) Hydrophilic head
B) Sugar side chain
C) Hydrophobic fatty acid tail
D) Cholesterol

Correct Answer:
C) Hydrophobic fatty acid tail
What is the name of this structure?
A) Hydrophobic fatty acid tail
B) Sugar side chain
C) Hydrophilic head
D) Cholesterol

Correct Answer:
B) Sugar side chain
What is the name of this structure?
A) Hydrophobic fatty acid tail
B) Sugar side chain
C) Cholesterol
D) Secondary protein

Correct Answer:
C) Cholesterol
The phospholipid head repels water.
A) Can both repel and attract water depending on its electrical current
B) False
C) True
D) None of these

Correct Answer:
B) False
The phospholipid bilayer contains:
A) Carbohydrates
B) Proteins
C) Cholesterol
D) All of these

Correct Answer:
D) All of these
This process, engulfing of substances via the membrane, is known as:
A) Myocytosis
B) Exocytosis
C) Econcytosis
D) Endocytosis

Correct Answer:
D) Endocytosis
Which molecules are non-polar?
A) Vitamins
B) All of these
C) Carbon dioxide
D) Oxygen

Correct Answer:
B) All of these
What is this model called?
A) Fluid monarchy
B) Static mosaic
C) Rough mosaic
D) Fluid mosaic

Correct Answer:
D) Fluid mosaic
Pathogens often exploit characteristics of the cell membrane to gain entry. Which structural feature of the membrane is most directly involved in this process?
A) Integral membrane proteins that act as receptors for pathogen attachment
B) Cholesterol molecules that rigidify the membrane and block all invaders
C) The hydrophobic core that prevents all molecular movement
D) Peripheral proteins that detach during infection and create membrane pores

Correct Answer:
A) Integral membrane proteins that act as receptors for pathogen attachment


